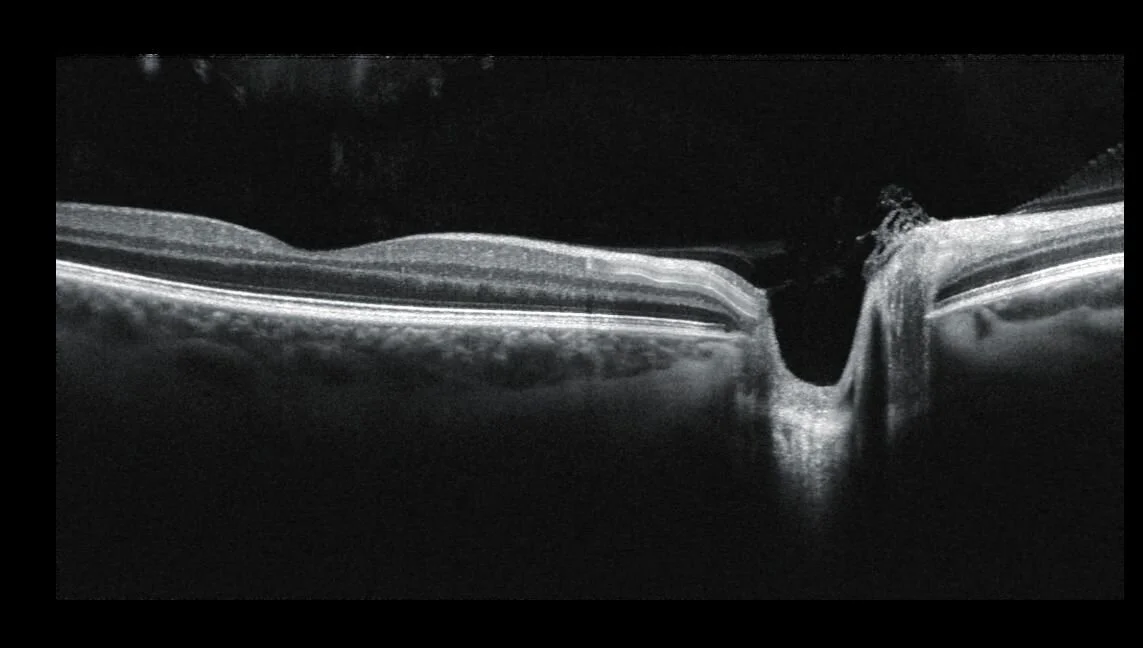

Our services.
Spectacles
At Latimer Eye Care we have a wide range of frames to choose from for ladies, mens and children. It is important that you feel comfortable in your new glasses so we take time to adjust your frames as necessary and discuss various lens options with you.
Eye Examinations
Regular eye examinations are advised not only to ensure that you have the best vision possible but to check both eye and general health. As qualified optometrists we can help in the early detection of blood pressure, cholesterol, diabetes and thyroid problems.
Contact Lenses
Contact lenses are a popular alternative or addition to wearing glasses. We are happy yo discuss your needs and requirements with you and find you the best and most suitable type of contact lenses.
Repairs and Adjustments
On collection of your new glasses from Latimer Eye Care we will check both the vision and the fit. Thereafter we are always happy to adjust or repair spectacles as necessary, using our on-site lab and trained technician.
OCT
3D Optical Coherence Tomography is a completely painless and highly advanced eye scan for people of all ages, which can identify a number of common and potentially serious conditions. We are among a growing number of professional optometrists who provide this service.
MiYOSMART
Myopia, or short sightedness, is becoming increasing common. It is even estimated that half of the global population could be short sighted by 2050!
Unfortunately, being short sighted is not only inconvenient, but it can also increase your risks for certain long term eye conditions. Therefore spotting this early on can make all the difference….
Special Needs
At Latimer Eye Care we are always happy to discuss how best to make someone’s practice visit as relaxed and stress free as possible. This may mean familiarisation visits, a visual story or just meeting us beforehand. We have experience in this area so please ask us how we can help.